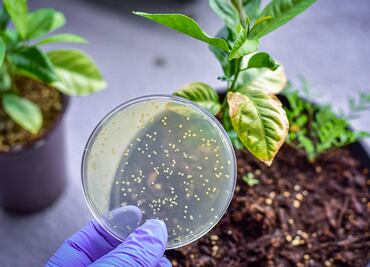

Ciencia y Salud30/09/2021
Procedentes de los cinco continentes, científicas son reconocidas y premiadas por la Unesco
Estas investigadoras están involucradas en el avance de tratamientos contra el Covid-19, cáncer y dengue
Estas investigadoras están involucradas en el avance de tratamientos contra el Covid-19, cáncer y dengue